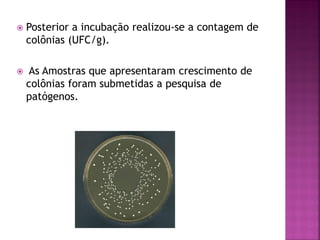
   Posterior a incubação realizou-se a contagem de
    colônias (UFC/g).

   As Amostras que apresentaram crescimento de
    colônias foram submetidas a pesquisa de
    patógenos.

O documento analisa a qualidade microbiológica de amostras de água purificada, matérias-primas e produtos semi-acabados de farmácias de manipulação em Goiânia. Verificou-se que a água deionizada apresentava os maiores índices de contaminação microbiana. A maioria das outras amostras estava dentro dos limites estabelecidos. Melhorias na purificação da água utilizada nas farmácias são necessárias.